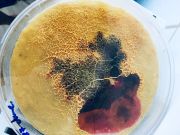

This special page shows all uploaded files.
| Date | Name | Thumbnail | Size | Description | Versions |
|---|---|---|---|---|---|
| 10:04, 31 July 2019 | Das triadische Ballett-Oskar Schlemmer.mp3 (file) | 9.58 MB | File uploaded with MsUpload | 1 | |
| 10:03, 31 July 2019 | Das Triadische Ballet-DJglove.mp3 (file) | 2.49 MB | File uploaded with MsUpload | 1 | |
| 09:44, 31 July 2019 | ARDUINO DJglove Carlos Garcia Fernandez.ino (file) | 957 bytes | File uploaded with MsUpload | 1 | |
| 09:43, 31 July 2019 | MAX DJglove Carlos Garcia Fernandez.maxpat (file) | 34 KB | File uploaded with MsUpload | 1 | |
| 09:07, 31 July 2019 | DJglove carlos garcia fernandez P5.JPG (file) |  |
2.99 MB | File uploaded with MsUpload | 1 |
| 08:53, 31 July 2019 | DJglove carlos garcia fernandez 6 arduino.png (file) |  |
5.99 MB | File uploaded with MsUpload | 2 |
| 08:52, 31 July 2019 | DJglove carlos garcia fernandez 5 arduino con.png (file) |  |
773 KB | File uploaded with MsUpload | 2 |
| 08:52, 31 July 2019 | DJglove carlos garcia fernandez 4 echo.png (file) |  |
712 KB | File uploaded with MsUpload | 2 |
| 08:52, 31 July 2019 | DJglove carlos garcia fernandez 3 sounds.png (file) |  |
675 KB | File uploaded with MsUpload | 2 |
| 08:52, 31 July 2019 | DJglove carlos garcia fernandez 2 audio.png (file) |  |
806 KB | File uploaded with MsUpload | 2 |
| 08:52, 31 July 2019 | DJglove carlos garcia fernandez 1.png (file) |  |
547 KB | File uploaded with MsUpload | 2 |
| 08:39, 31 July 2019 | DJglove carlos garcia fernandez P4.JPG (file) |  |
2.82 MB | File uploaded with MsUpload | 1 |
| 08:38, 31 July 2019 | DJglove carlos garcia fernandez P3.JPG (file) |  |
2.73 MB | File uploaded with MsUpload | 1 |
| 08:38, 31 July 2019 | DJglove carlos garcia fernandez P2.JPG (file) |  |
2.7 MB | File uploaded with MsUpload | 1 |
| 08:38, 31 July 2019 | DJglove carlos garcia fernandez P1.JPG (file) |  |
3.58 MB | File uploaded with MsUpload | 1 |
| 08:27, 26 July 2019 | ORGANISMUS MANIFESTO CARLOS GARCIA FERNANDEZ EXHIBITION 10.JPG (file) |  |
2.03 MB | File uploaded with MsUpload | 1 |
| 08:27, 26 July 2019 | ORGANISMUS MANIFESTO CARLOS GARCIA FERNANDEZ EXHIBITION 9.JPG (file) |  |
1.97 MB | File uploaded with MsUpload | 1 |
| 08:22, 26 July 2019 | ORGANISMUS MANIFESTO CARLOS GARCIA FERNANDEZ EXHIBITION 11.JPG (file) |  |
1 MB | File uploaded with MsUpload | 1 |
| 08:21, 26 July 2019 | ORGANISMUS MANIFESTO CARLOS GARCIA FERNANDEZ EXHIBITION 8.JPG (file) |  |
2.44 MB | File uploaded with MsUpload | 1 |
| 08:21, 26 July 2019 | ORGANISMUS MANIFESTO CARLOS GARCIA FERNANDEZ EXHIBITION 7.JPG (file) |  |
2.44 MB | File uploaded with MsUpload | 1 |
| 08:21, 26 July 2019 | ORGANISMUS MANIFESTO CARLOS GARCIA FERNANDEZ EXHIBITION 6.JPG (file) |  |
2.28 MB | File uploaded with MsUpload | 1 |
| 08:14, 26 July 2019 | ORGANISMUS MANIFESTO CARLOS GARCIA FERNANDEZ EXHIBITION 5.JPG (file) |  |
2.29 MB | File uploaded with MsUpload | 2 |
| 09:05, 25 July 2019 | ORGANISMUS MANIFESTO CARLOS GARCIA FERNANDEZ EXHIBITION 4.JPG (file) |  |
2.91 MB | File uploaded with MsUpload | 1 |
| 09:05, 25 July 2019 | ORGANISMUS MANIFESTO CARLOS GARCIA FERNANDEZ EXHIBITION 3.JPG (file) |  |
2.66 MB | File uploaded with MsUpload | 1 |
| 09:05, 25 July 2019 | ORGANISMUS MANIFESTO CARLOS GARCIA FERNANDEZ EXHIBITION 2.JPG (file) |  |
2.63 MB | File uploaded with MsUpload | 2 |
| 09:04, 25 July 2019 | ORGANISMUS MANIFESTO CARLOS GARCIA FERNANDEZ EXHIBITION 1.JPG (file) |  |
2.34 MB | File uploaded with MsUpload | 1 |
| 08:39, 25 July 2019 | ORGANISMUS MANIFESTO CARLOS GARCIA FERNANDEZ EXHIBITION 4.jpeg (file) |  |
2.78 MB | File uploaded with MsUpload | 1 |
| 08:38, 25 July 2019 | ORGANISMUS MANIFESTO CARLOS GARCIA FERNANDEZ EXHIBITION 3.jpeg (file) |  |
2.66 MB | File uploaded with MsUpload | 1 |
| 08:36, 25 July 2019 | ORGANISMUS MANIFESTO CARLOS GARCIA FERNANDEZ EXHIBITION 1.JPG.JPG (file) |  |
1.81 MB | File uploaded with MsUpload | 1 |
| 08:32, 25 July 2019 | Ex 1.JPG (file) |  |
1.81 MB | File uploaded with MsUpload | 1 |
| 08:29, 25 July 2019 | Poster Frame MANIFESTOS.JPG (file) |  |
1.4 MB | File uploaded with MsUpload | 1 |
| 08:21, 25 July 2019 | POSTER.JPG (file) |  |
1.42 MB | File uploaded with MsUpload | 1 |
| 08:18, 25 July 2019 | ORGANISMUS MANIFESTO SHIELD.JPG (file) |  |
33 KB | File uploaded with MsUpload | 1 |
| 08:18, 25 July 2019 | ORGANISMUS MANIFESTO POSTER.JPG (file) |  |
38 KB | File uploaded with MsUpload | 1 |
| 08:09, 25 July 2019 | ORGANISMUS MANIFESTO DEVICE4.JPG.JPG (file) |  |
2.68 MB | File uploaded with MsUpload | 1 |
| 08:04, 25 July 2019 | WORKING LEDS.MOV (file) | 8.15 MB | File uploaded with MsUpload | 1 | |
| 07:52, 25 July 2019 | ORGANISMUS MANIFESTO DEVICE3.JPG (file) | |
407 KB | File uploaded with MsUpload | 1 |
| 07:52, 25 July 2019 | ORGANISMUS MANIFESTO DEVICE2.JPG (file) |  |
3.13 MB | File uploaded with MsUpload | 1 |
| 07:52, 25 July 2019 | ORGANISMUS MANIFESTO DEVICE1.JPG (file) |  |
3.17 MB | File uploaded with MsUpload | 1 |
| 14:14, 19 June 2019 | Organisms Manifesto paper cgf.jpg (file) |  |
3.2 MB | File uploaded with MsUpload | 1 |
| 14:03, 19 June 2019 | Morse code device cgf.jpg (file) |  |
3.12 MB | File uploaded with MsUpload | 1 |
| 14:00, 19 June 2019 | Organisms Manifesto cgf.jpg (file) |  |
469 KB | File uploaded with MsUpload | 1 |
| 21:44, 5 June 2019 | Remote glove prototype.jpg (file) |  |
3 MB | File uploaded with MsUpload | 1 |
| 09:32, 1 June 2019 | Morse code neopixel.ino (file) | 8 KB | File uploaded with MsUpload | 1 | |
| 09:25, 1 June 2019 | 2019 06 1 LED TESTING.JPG (file) |  |
2.86 MB | File uploaded with MsUpload | 1 |
| 09:32, 15 May 2019 | Cgf prototype bioDJ 01.jpg (file) |  |
5.85 MB | File uploaded with MsUpload | 1 |
| 20:20, 14 May 2019 | Cgf prototype 01.jpg (file) |  |
6.12 MB | File uploaded with MsUpload | 1 |
| 21:04, 8 May 2019 | Cgf VIDEO5.maxpat (file) | 8 KB | File uploaded with MsUpload | 1 | |
| 21:04, 8 May 2019 | Cgf VIDEO4.maxpat (file) | 4 KB | File uploaded with MsUpload | 1 | |
| 21:04, 8 May 2019 | Cgf VIDEO3.maxpat (file) | 5 KB | File uploaded with MsUpload | 1 |